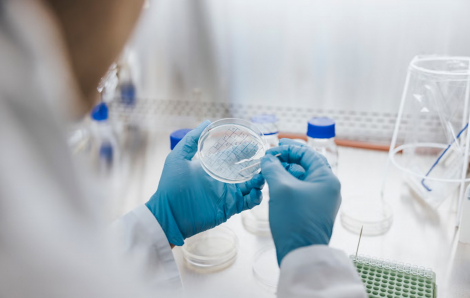
Nguy cơ từ loại nấm mốc siêu kháng thuốc có thể lây nhiễm cho hàng triệu người

Kết quả tìm kiếm cho "moc nam"
Kết quả 1 - 12 trong khoảng 56

Dự án cao tốc TPHCM - Mộc Bài gần 20.000 tỉ đồng đang được đẩy nhanh tiến độ, dự kiến khởi công hạng mục chính vào tháng 4/2026.

Chắc chắn bạn không muốn mùi ẩm mốc cũ tồn tại trong nhà mình. Nếu bạn phớt lờ, khả năng mùi này tự biến mất là rất thấp.

Khu vực cửa khẩu quốc gia Giang Thành là một trong những nơi tập kết lúa từ Campuchia chuyển về Việt Nam. Ở đây đã hình thành bãi bốc xếp lúa gạo.

UBND TPHCM vừa có tờ trình gửi HĐND TPHCM chủ trương sử dụng vốn đầu tư phát triển từ ngân sách thành phố để hỗ trợ tỉnh Tây Ninh 1.806 tỉ đồng.

Nếu bạn để khăn ướt thành đống hoặc quần áo tập gym trong túi và sau đó chúng có mùi kinh khủng, hãy tiêu diệt nấm mốc và loại bỏ mùi.

Về Hội An, ghé làng Kim Bồng, bạn sẽ được chìm đắm trong ký ức chợ quê, với tiếng sóng ru bờ và hòa vào nhịp hò khoan trong khói lam chiều.
Nghiên cứu từ Anh cho thấy, nhiễm trùng nấm sẽ trở thành nguyên nhân gây ra hàng triệu ca tử vong trên toàn thế giới mỗi năm.

Có 2 món này sẵn trong tủ không những giảm bớt gánh nặng nội trợ mà còn giúp tôi nuôi dưỡng cảm giác đủ đầy.

Khoảnh khắc các nàng hậu để mặt mộc luôn được nhiều người chú ý bởi đây là nhan sắc thật. Khi không còn lớp make up, dễ để lộ khuyết điểm.

Có 2 món này sẵn trong tủ không những giảm bớt gánh nặng nội trợ mà còn giúp tôi nuôi dưỡng cảm giác đủ đầy.

Mùa hè này, nếu bạn muốn đi trốn cái nóng, muốn lạc vào chốn thiên nhiên đầy mơ mộng, hãy thử tìm về Mộc Châu.

Tối 6/5, chương trình nghệ thuật mang tên "Điện Biên Phủ: Mốc vàng lịch sử" diễn ra tại Quảng trường 7/5, tỉnh Điện Biên.